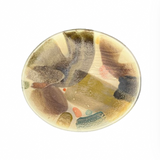

Klein Reid
Rio Abricó Platter, Extra Large
Free shipping on orders over $250
Pickup available at AnnSandra
Usually ready in 24 hours
Klein Reid’s new Rio collection features statement vessels hand-produced in their bespoke porcelain. Each piece is finished with a one-of-a-kind hand-painted palette of glazes. These melt and fuse in the firing creating lush, unique surfaces of surprising depth, with hues range from bold and painterly to subtle and watercolor-like.
Details
3" x 18.5"
Product information
We offer free standard shipping on all orders over $250, applied automatically at checkout. This offer cannot be combined with any other offers, discounts or promo codes.
Most products are eligible for return within 7 days for a refund or 15 days for store credit. Please note: some products marked as Special Order may not be eligible for return. Please email or call us at (240) 744-7015 us before purchasing a product marked as special order, we’re happy to provide you with return policy details on the specific item you’d like to purchase. Markdowns, custom orders and some items marked “Special Order” are FINAL SALE and not eligible for return or exchange.
AnnSandra does not cover the cost of return shipping. Original shipping fees are non-refundable. Items must be in original condition.
Recently viewed products
We saw you eyeing these...